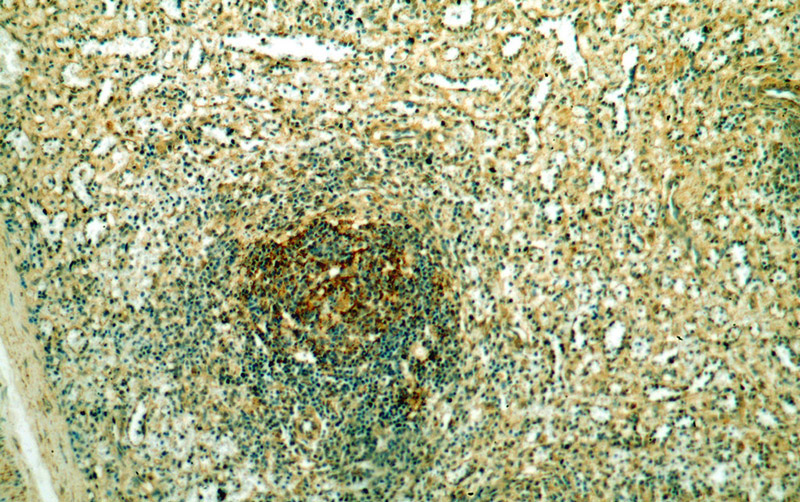
Immunohistochemical of paraffin-embedded human spleen using Catalog No:116290(TNFR2 antibody) at dilution of 1:50 (under 10x lens)
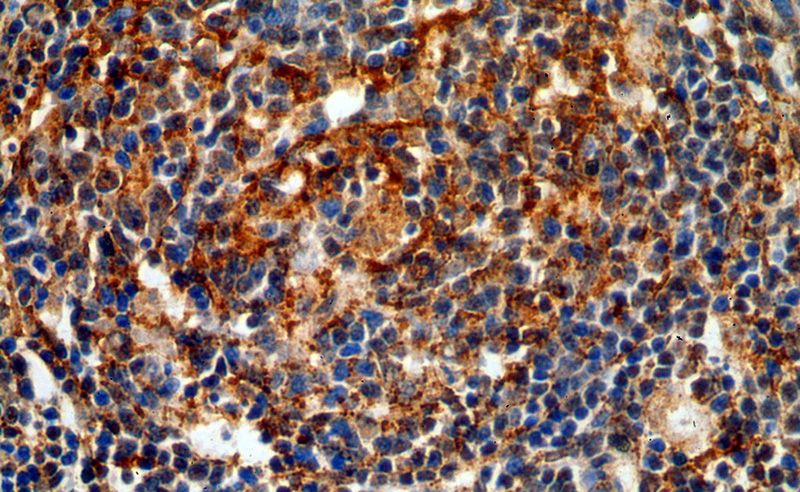
Immunohistochemical of paraffin-embedded human spleen using Catalog No:116290(TNFR2 antibody) at dilution of 1:50 (under 40x lens)

-
Product Name
TNFR2 antibody
- Documents
-
Description
TNFR2 Rabbit Polyclonal antibody. Positive WB detected in Jurkat cells, HEK-293 cells, MCF7 cells, mouse thymus tissue. Positive IP detected in HEK-293 cells. Positive FC detected in HeLa cells. Positive IHC detected in human spleen tissue. Positive IF detected in Hela cells. Observed molecular weight by Western-blot: 75 kDa
-
Tested applications
ELISA, WB, IHC, IF, FC, IP
-
Species reactivity
Human, Mouse; other species not tested.
-
Alternative names
CD120b antibody; Etanercept antibody; p75 antibody; p75TNFR antibody; p80 TNF alpha receptor antibody; TBP 2 antibody; TBPII antibody; TNF R II antibody; TNF R2 antibody; TNF R75 antibody; TNF Receptor 2 antibody; TNF Receptor II antibody; TNF RII antibody; TNFBR antibody; TNFR II antibody; TNFR1B antibody; TNFR2 antibody; TNFR80 antibody; TNFRSF1B antibody
-
Isotype
Rabbit IgG
-
Preparation
This antibody was obtained by immunization of TNFR2 recombinant protein (Accession Number: NM_001066). Purification method: Antigen affinity purified.
-
Clonality
Polyclonal
-
Formulation
PBS with 0.02% sodium azide and 50% glycerol pH 7.3.
-
Storage instructions
Store at -20℃. DO NOT ALIQUOT
-
Applications
Recommended Dilution:
WB: 1:200-1:2000
IP: 1:200-1:2000
IHC: 1:20-1:200
IF: 1:10-1:100
-
Validations

Jurkat cells were subjected to SDS PAGE followed by western blot with Catalog No:116290(TNFR2 antibody) at dilution of 1:500

1X10^6 HeLa cells were stained with 0.5ug TNFR2 antibody (Catalog No:116290, red) and control antibody (blue). Fixed with 4% PFA blocked with 3% BSA (30 min). FITC-Goat anti-Rabbit IgG with dilution 1:100.
Immunohistochemical of paraffin-embedded human spleen using Catalog No:116290(TNFR2 antibody) at dilution of 1:50 (under 10x lens)
Immunohistochemical of paraffin-embedded human spleen using Catalog No:116290(TNFR2 antibody) at dilution of 1:50 (under 40x lens)

Immunofluorescent analysis of Hela cells, using TNFRSF1B antibody Catalog No:116290 at 1:25 dilution and Rhodamine-labeled goat anti-rabbit IgG (red).

IP Result of anti-TNFR2 (IP:Catalog No:116290, 4ug; Detection:Catalog No:116290 1:500) with HEK-293 cells lysate 1200ug.
-
Background
Tumor necrosis factor-alpha (TNFA/TNFSF2) is amultifunctional cytokine that plays a key role in regulating inflammation, immune functions, host defense, and apoptosis (PMID: 16407280). TNFA signals through two distinct cell surface receptors, TNFR1 (TNFRSF1A, CD120a, p55) and TNFR2 (TNFRSF1B, CD120b, p75). TNFR1 is widely expressed, whereas TNFR2 exhibits more restricted expression, being found on CD4 and CD8 T lymphocytes, endothelial cells, microglia, oligodendrocytes, neuron subtypes, cardiac myocytes, thymocytes and human mesenchymal stem cells (PMID: 20489699; 22374304). In contrast to TNFR1, TNFR2 does not have a death domain. TNFR2 only signals for antiapoptotic reactions. However, recent evidence indicates that TNFR2 also signals to induce TRAF2 degradation (PMID: 22374304). Various defects in the TNFR2 pathway, due to polymorphisms in the TNFR2 gene, upregulated expression of TNFR2 and TNFR2 shedding, have been implicated in the pathology of several autoimmune disorders (PMID: 20489699).
-
References
- Kallenborn-Gerhardt W, Hohmann SW, Syhr KM. Nox2-dependent signaling between macrophages and sensory neurons contributes to neuropathic pain hypersensitivity. Pain. 155(10):2161-70. 2014.
Related Products / Services
Please note: All products are "FOR RESEARCH USE ONLY AND ARE NOT INTENDED FOR DIAGNOSTIC OR THERAPEUTIC USE"
